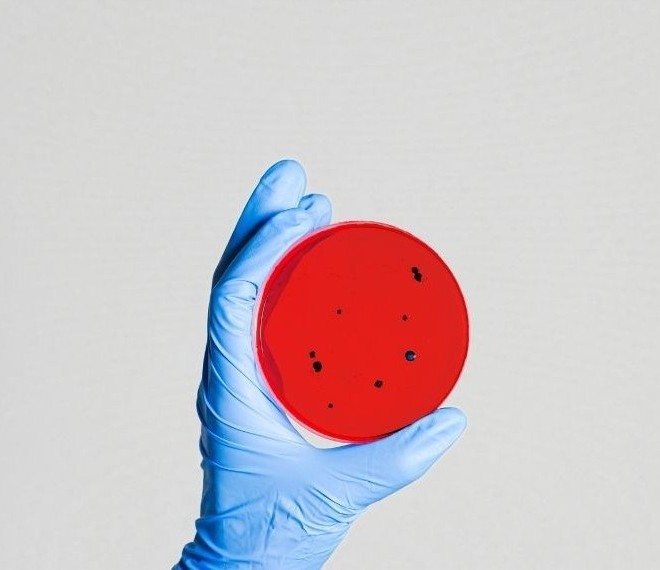

Por Ricardo Mazzon – Departamento de Microbiologia – Universidade Federal de Santa Catarina (UFSC)
O corpo humano é colonizado em muitas partes por bactérias, fungos, vírus e protozoários que, quando suas populações são mantidas em número controlado e restritas aos locais que normalmente habitam, contribuem positivamente para o funcionamento do organismo na medida que protegem tais tecidos contra infecções de microrganismos exógenos, contribuem para a ciclagem de nutrientes nestes nichos além de produzir vitaminas e degradar toxinas. Ao conjunto destes microrganismos que habitam um determinado sítio anatômico do corpo humano é dado o nome de Microbiota residente (e.g. microbiota residente da pele, microbiota residente da boca, microbiota residente do trato gastrointestinal e etc). Já é bem estabelecido na literatura científica que, esses microrganismos residentes em determinada região do nosso corpo, quando transportados para regiões nas quais eles não são habitantes usuais, podem se tornar agentes de infecção evento frequentemente referido como uma infecção endógena.
Muitos estudos feitos com as microbiotas do corpo humano apontam potencial interferência destes microrganismos ou repercussão sobre eles em manifestações como obesidade, autismo, diabetes, adicção por drogas, dermatites, doenças intestinais, doenças hepáticas, doenças cardiovasculares, ansiedade, depressão, câncer etc.
Embora um grande estudo de coorte prospectivo realizado por Jia e colaboradores (2020) não tenha identificado associação clara entre a doença periodontal e o risco geral de câncer de mama, este estudo mostrou um risco aumentado sugestivo de câncer de mama invasivo e risco reduzido de carcinoma ductal in situ independentemente na mesma população.
Continuar lendo